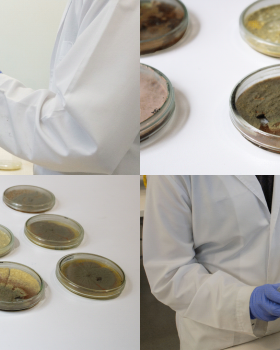
ARQT 3336 机器人制造与生物材料工具深化单元

项目时间全部1911年1915年1920年1930年1931年1939年1949年1952年1956年1957年1959年1970年1973年1975年1978年1981年1984年1985年1986年1987年1991年1992年1993年1994年1995年1996年1997年1998年1999年2000年2001年2002年2003年2004年2005年2006年2007年2008年2009年2010年2011年2012年2013年2014年2015年2016年2017年2018年2019年2020年2021年2022年2023年2024年2025年
客服
消息
收藏
下载
最近